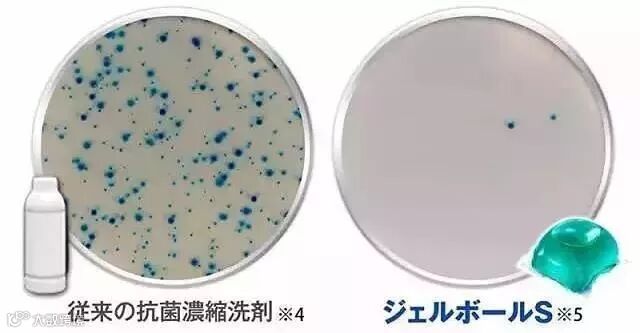

每个爱打扮的女孩都有一个烦恼,每到周末就发现洗衣篮怎么又满了,平时回家只想躺着撸狗吃零食打游戏,哪有心思花大半天时间去打理衣服~

宝洁公司,是世界上最大的日用消费品公司之一,旗下独家研发的高科技P&G洗衣凝珠,在Cosme大赏、Trendy杂志柔顺洗涤部门,排行榜全部名列前茅!

就是这样小小一颗即可做到清洁、柔软二合一,使洗后的衣物和新的一样,还自带一股淡淡的清香~~

那么它到底哪里厉害呢?
清洁力
作为洗衣凝珠,最重要的评判标准当然还是清洁力!
撒上了咖啡的白T恤用保洁的洗衣凝珠洗过以后一点污渍的痕迹都看不出来,颜色依旧光鲜亮丽。

还有陈旧泛黄的旧毛衣,不光洗的干净洁白,拼色的部分也没有丝毫的染色晕色。

这都是因为凝珠内包含了特有的冷水酶、艳色螯合剂等成分,另去污、固色都能轻松兼顾,各色衣服放在一起洗也不会染色。

清洗前后效果对比
▼

多重效能表面活性剂甚至超过90%,高于普通的洗衣液含量一倍多,因此P&G凝珠相比普通洗衣粉、洗衣液清洁能力更节能高效。

除了各种污渍,宝洁的洗衣凝珠还有着超强清洁油污的能力,一般洗衣液洗衣粉较难清除的油污它也能够轻松应对。
50倍抗菌
不过上面那些还只是基础的清洁力,凝珠最厉害的还是50倍除菌的配方。
衣服如果在清洗以后总是潮湿不干就会容易滋生细菌,再加上洗衣机用久了里面会有很多看不见的霉斑,洗衣剂的杀菌功效就显得尤为重要了。
抗菌实验18小时后的对比效果
左为普通洗衣液细菌滋生
右为洗衣凝珠细菌几乎为零
除了洗干净衣服上本来附着的细菌,它还能持续抗菌,防止由于衣服的不干净导致皮肤过敏、体癣、湿疹等。自己在家就能杀菌消毒,真的比送到干洗店还放心~

芳香
浓缩了“Ariel、Lenor、Febreze"三大除臭精华,外加2倍浓缩香氛配方,配合除菌抑菌成分,即使是阴天晾衣服也不会有讨厌的霉味。

高科技保护膜
要说凝珠最为神奇与高科技的一点就是,采用特殊材质制成的那层保护膜,保证可承受15KG的重量不爆裂。

但是遇到水的时候就可以立刻溶解。

无需计量使用,无需拆膜,一颗直接搞定一桶。出门旅行携带也很方便。

性质温和
P&G洗衣凝珠的酸碱度PH值接近中性,不会伤及皮肤和衣物,优质清洁还健康环保。

不含荧光剂,洗净以后无残留,所以既不会对皮肤造成伤害与过敏现象,更不会对衣物造成任何伤害,优质清洁更健康环保,保证家人特别是小孩的安全健康。
使用方法
1、把一颗啫喱球放到洗衣机的下方,再放上衣物,然后关起洗衣机门,注水后啫喱球会自动溶解。
2、每次放一颗洗衣球即可满足一桶的洗衣量,使用更加方便省力。

【注意】:取洗衣球的时候一定要干手,因为遇到水会立即溶解。

方便、便宜又好用的洗衣凝珠你心动了没有呀,高科技发明真的是让生活品质越来越高,越来越便捷啦~

紫藤全球仓您品质生活的引导者
扫描二维码
更多精品 尽在紫藤全球仓
紫藤全球仓 进口商品专家
紫藤全球仓 您身边的世界商城


